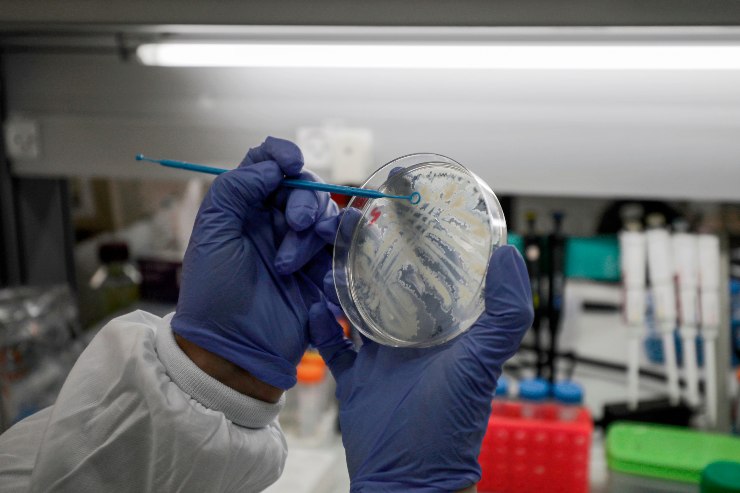

Italia solidale mostra tutto il suo cuore in questa emergenza coronavirus. I ristoratori di Milano preparano pasti per il personale sanitario
Non riuscivanoi più a stare senza cucinare. Con questa “scusa” alcuni ristoratori milanesi si sono adoperati per cucinare pasti al personale sanitario. Un modo per sostenere lo sforzo degli eroi di questa storica e difficile disavventura italiana. Così Luca Rudilosso e gli altri quattro titolari del ristorante siciliano SlowSud, nel centro di Milano, sono tornati ai fornelli: «Ovviamente non abbiamo coinvolto il personale, ma siamo noi cinque a gestire tutto in maniera artigianale. Umberto, in cucina dal mattino, prepara tutto quello che si può fare in grandi quantità: pasta al forno, pasta alla norma e non mancano i cannoli. Io, Anthony e Andrea facciamo i corrieri in giro per gli ospedali, anche per conto degli altri ristoranti. Alessandra organizza il calendario: ci si coordina in base alla disponibilità dei ristoranti, alla posizione e ai mezzi di trasporto».
Italia solidale, ecco la filiera a sostegno dei sanitari
Rudilosso parla di altri ristoranti perché alla loro iniziativa hanno aderito Miscusi, Fud, Muu Muzzarella, Li Mastri, Fancytoast, Loredani, Star Zagros Kebabbar e Gnomo. «La cosa più commovente è intravedere, dietro la mascherina, il sorriso di medici e infermieri che ricevono un piatto caldo». I singoli ristoratori sono stati aiutati nel coordinamento da Ristoratore Top, un’azienda di consulenza e formazione specializzata nel marketing per la ristorazione. L’onlus Sos Lambrate-Anpas ha messo a disposizione il proprio furgone per le consegne.«Gli ospedali che siamo riusciti a raggiungere con il nostro servizio e con i quali abbiamo già stilato un calendario di consegne per questa settimana sono il Fatebenefratelli, il San Giuseppe, il Sacco, il San Raffaele, il Policlinico e il Bassini di Cinisello Balsamo». Il consorzio di ristoratori solidali che hanno risposto all’appello di SlowSud è in grado di fornire gratuitamente a infermieri, medici e personale sanitario circa 300 pasti al giorno“.
Leggi anche > Cacciari nefasto verso l’Europa
Leggi anche > La riconversione del tessile









